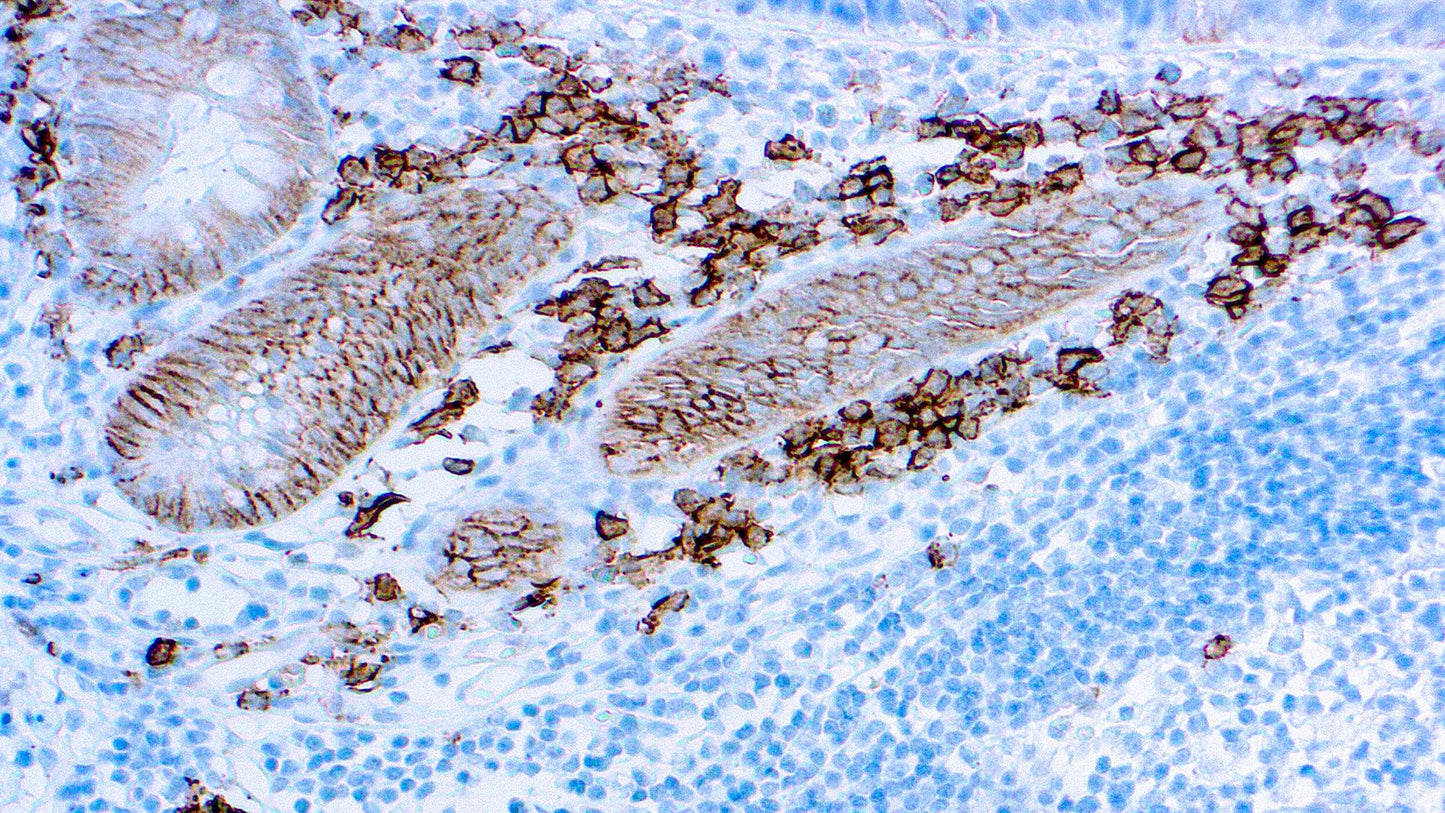
CD138

1
/
of
1
Dbiosys
SKU:Mob588
CD138
CD138
Regular price
$496.00 USD
Regular price
Sale price
$496.00 USD
Unit price
/
per
Shipping calculated at checkout.
Couldn't load pickup availability
CD138, also known as Syndecan-1, is a member of the transmembrane heparan sulfate proteoglycan family, acts as an extracellular matrix receptor and is involved in many cellular functions, including cell-cell adhesion and cell-matrix adhesion. CD138 expression is found in both hematopoietic and non-hematopoietic cells. In the hematopoietic system, CD138 labels plasma cells. It is an excellent marker for plasmacytic differentiation within the spectrum of hematologic malignancy. Among non-hematolymphoid cells, CD138 reactivity is observed in many types of epithelial cells and stoma cells in both normal and tumor tissues.
Share